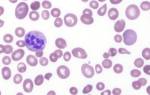

Настораживающие события
Первые проявления инсульта зависят от типа нарушения: ишемии или кровоизлияния, хотя разновидность имеет меньшую роль.
Симптомы кровоизлияния обычно проявляются ярче и быстрее. При обширных поражениях вероятность летального исхода возрастает.
Если человек внезапно ощущает «дурноту», можно заподозрить сосудистые проблемы по следующим признакам, указывающим на инсульт:
- Онемение в определенных участках тела (лицо, конечности);
- Головная боль;
- Потеря ориентации в пространстве;
- Двоение в глазах и другие нарушения зрения;
- Тошнота, рвота, головокружение;
- Проблемы с движением и чувствительностью.
Эти симптомы могут быть распознаны (даже самим пациентом) только в сознании. Однако острое нарушение мозгового кровообращения часто сопровождается обморочным состоянием, из которого пациент может не прийти в себя.
Не стоит пытаться поднять или усадить человека, особенно если он в бессознательном состоянии. Инсульт может быть настолько серьезным, что неоправданные действия лишь ухудшат состояние пострадавшего.
Правильные действия окружающих должны быть направлены на то, чтобы не навредить пациенту. Нужно аккуратно расположить его в удобном положении. Если человек в сознании, можно попросить его улыбнуться или показать язык. Неспособность выполнить эти простые действия, потеря сознания, нарушения речи, невозможность двигаться или изменить положение тела — это первые признаки инсульта, которые должны побудить окружающих немедленно вызвать службу экстренной медицинской помощи и дождаться медиков.
Инсульты в первую очередь угрожают пожилым людям. Однако, если рассматривать их по половому признаку, острое нарушение мозгового кровообращения у женщин происходит в более позднем возрасте (после менопаузы, когда защитная роль эстрогенов ослабевает), в то время как инсульт у мужчин может случиться значительно раньше, и в сорокалетнем возрасте это уже не редкость.
Учитывая, что каждый может стать свидетелем такой ситуации и от его действий может зависеть жизнь пострадавшего, важно обратить внимание на общие признаки инсульта, характерные для обоих типов острых нарушений мозгового кровообращения.
Врачи подчеркивают важность раннего распознавания признаков инсульта, так как это может спасти жизнь пациента. К предвестникам относятся головные боли, головокружение, слабость в конечностях и нарушение речи. Первые проявления могут включать внезапное онемение одной стороны тела, затруднение в произношении слов и потерю координации. Симптомы инсульта делятся на ишемические и геморрагические. Ишемический инсульт возникает из-за блокировки кровеносного сосуда, что приводит к недостатку кислорода в мозге, тогда как геморрагический инсульт связан с разрывом сосуда и кровоизлиянием. Важно помнить, что при появлении любых из этих симптомов необходимо немедленно обратиться за медицинской помощью, так как время играет решающую роль в восстановлении.

Первые признаки и симптомы инсульта – 4 проверки
| Признак | Ишемический инсульт | Геморрагический инсульт |
|---|---|---|
| Предвестники (мини-инсульты, TIA) | Внезапная слабость или онемение лица, руки или ноги (часто с одной стороны тела), нарушение речи, зрения, координации; проходят в течение нескольких минут или часов. | Редкие, могут проявляться как внезапная сильная головная боль. |
| Первые проявления | Внезапная слабость или паралич лица, руки или ноги (часто с одной стороны тела), нарушение речи (афазия), спутанность сознания, потеря зрения (в одном или обоих глазах), головокружение, потеря координации, внезапная сильная головная боль (редко). | Внезапная, сильная головная боль (часто “худшая в жизни”), внезапная потеря сознания, тошнота, рвота, быстрое развитие неврологических симптомов (паралич, нарушение речи, зрения). |
| Симптомы: Класс двигательных нарушений | Слабость, паралич, парез одной стороны тела (гемипарез), нарушение координации, атакcия. | Слабость, паралич, парез, возможны судороги. |
| Симптомы: Класс речевых нарушений | Афазия (нарушение речи), дизартрия (нарушение артикуляции). | Афазия (нарушение речи), дизартрия (нарушение артикуляции). |
| Симптомы: Класс сенсорных нарушений | Онемение, покалывание, потеря чувствительности на одной стороне тела. | Онемение, покалывание, потеря чувствительности, возможны нарушения зрения. |
| Симптомы: Класс зрительных нарушений | Потеря зрения в одном или обоих глазах, двоение в глазах. | Потеря зрения в одном или обоих глазах, двоение в глазах, возможны кровоизлияния в сетчатку. |
| Симптомы: Класс когнитивных нарушений | Спутанность сознания, дезориентация, потеря памяти. | Спутанность сознания, дезориентация, потеря памяти, возможна кома. |
| Головная боль | Редко бывает сильной, может отсутствовать. | Часто сильная, внезапная, “худшая в жизни”. |
| Тошнота и рвота | Редко. | Часто. |
| Потеря сознания | Редко. | Часто. |
| Диагностика | КТ или МРТ головного мозга (выявляет ишемию). | КТ или МРТ головного мозга (выявляет кровоизлияние). |
Общемозговые нарушения и неврологические расстройства
В остром периоде инсульта неврологи выделяют две основные группы нарушений.
Симптомы первой группы возникают из-за гипоксии, вызванной ишемией (инфарктом мозга), или повышением внутричерепного давления при кровоизлиянии (геморрагический инсульт). Общемозговые симптомы можно заподозрить при наличии:
- Интенсивной головной боли;
- Тошноты и рвоты;
- Изменений в сознании (от легкого помрачения до комы);
- Судорог.
Неврологические проявления инсульта второй группы указывают на поражение определенной области головного мозга. Эти проявления могут заметить не только медицинские работники, но и случайные свидетели:
- Нарушение или полная утрата двигательных функций конечностей на стороне, противоположной очагу поражения, снижение сухожильных рефлексов и мышечного тонуса (гемипарез или гемиплегия);
- На стороне, противоположной очагу поражения, может наблюдаться нарушение чувствительности (гемигипестезия);
- Изменение положения глаз – они могут смотреть в сторону поражения (парез взора), а на стороне поражения зрачок может быть расширен (мидриаз);
- Опущение уголка рта и сглаженность носогубной складки;
- Речевые нарушения при поражении доминирующего полушария (у правшей речь страдает при проблемах в левом полушарии, у левшей – наоборот);
- Появление патологических рефлексов, которые сложно определить без квалификации невролога, поэтому их выявлением должен заниматься специалист.
Важно отметить, что прогноз зависит от того, какой участок головного мозга подвергается ишемии или кровоизлиянию. Несмотря на схожесть симптомов инсульта для обоих типов острых нарушений мозгового кровообращения, различия в расположении пораженной зоны имеют свои особенности, интересные не только специалистам, но и читателям.
Инсульт — это серьезное заболевание, которое требует немедленного внимания. Люди часто упоминают о предвестниках, таких как головные боли, головокружение и временная потеря зрения. Первые проявления могут включать слабость в одной стороне тела, затруднения в речи и внезапную потерю координации. Симптомы инсульта делятся на несколько классов: ишемический инсульт возникает из-за блокировки кровеносного сосуда, тогда как геморрагический связан с разрывом сосуда и кровоизлиянием в мозг. Важно знать, что время имеет решающее значение — чем быстрее будет оказана помощь, тем больше шансов на восстановление. Осведомленность о признаках инсульта может спасти жизнь, поэтому важно делиться этой информацией с окружающими.

Страдания основных долей
Читателю будет интересно узнать, как проявляются симптомы инсульта в зависимости от пораженного отдела головного мозга. Упоминание о том, что затронута лобная или височная область, не дает полной картины без понимания функций центров, расположенных в этих зонах.
Субарахноидальное пространство
Подпаутинное (субарахноидальное) пространство — это область, заполненная спинномозговой жидкостью, расположенная между мягкой и подпаутинной оболочками мозга.
Кровоизлияние в это пространство всегда приводит к серьезным последствиям, угрожающим жизни пациента:
- Интенсивная головная боль;
- Ярко выраженные общемозговые симптомы;
- Наступление комы.

Ствол мозга
Неврологи считают, что наиболее опасным состоянием является поражение ствола мозга. В этом районе расположены жизненно важные нервные центры, отвечающие за функционирование организма, а также ядра черепных нервов. Вероятность летального исхода при кровоизлиянии в ствол мозга может достигать 90%.
Симптомы инсульта (кровоизлияния) при поражении ствола мозга выражены следующим образом:
- Резкая потеря сознания и возможное развитие комы;
- Двусторонние параличи и нарушения чувствительности;
- Проблемы с глотанием;
- Расстройства дыхательной и сердечно-сосудистой систем.
Желудочки мозга
Широкое кровоизлияние в полушариях часто приводит к прорыву в желудочки головного мозга, что создает серьезную угрозу для жизни пациента.
Симптомы данного типа инсульта:
- Внезапное ухудшение сознания;
- Коматозное состояние.
Мозжечок
Обширное кровоизлияние в мозжечок (затылочная область) может быстро вызвать отек и его вклинение в большое затылочное отверстие, что, к сожалению, может привести к летальному исходу.
Признаки инсульта в мозжечке:
- Сильная головная боль в затылочной области;
- Ярко выраженное головокружение;
- Рвота;
- Проблемы с координацией движений (человек не может удерживать вертикальное положение);
- Расстройства речи.
Лобные доли
Лобные доли играют ключевую роль в формировании функций, определяющих личность, таких как самооценка, критическое мышление, абстрактное восприятие и внимание. Повреждения этой области мозга могут вызывать различные симптомы, объединяемые под термином «лобная психика»:
- Изменения в личности;
- Возвращение примитивных рефлексов (например, хватательный и хоботковый);
- Повышенная импульсивность;
- Приступы агрессии;
- Апатия;
- Судороги.
В целом, поведение человека с поражением лобных долей меняется, но могут также проявляться и другие симптомы, характерные для острых нарушений мозгового кровообращения: двигательные и сенсорные расстройства, параличи и нарушения речи.
Теменная область
При повреждении теменной зоны ухудшается тактильная чувствительность. Утрачиваются навыки письма, чтения, счёта и ориентирования в пространстве. Человек также перестаёт распознавать знакомые объекты.
Височная доля
Патологии височной доли обычно проявляются следующими симптомами:
- Проблемы со слухом (глухота, шум в ушах);
- Утрата способности понимать родной язык и воспринимать звуки (музыка, пение птиц);
- Галлюцинации;
- Развитие височной эпилепсии.
Невозможно подробно охарактеризовать страдания всех отделов головного мозга отдельно. Общие признаки инсульта могут проявляться в разной степени при поражении любой области нервной системы.
Что видит невролог?
Как врач определяет, в каком участке головного мозга произошла авария? Это может быть лобная или теменная доля, или, не дай Бог, ствол мозга? В рамках небольшой статьи невозможно охватить все нюансы неврологической науки, но познакомиться с основами диагностики вполне реально.
Многие люди, не имеющие медицинского образования, слышали о том, что инсульты делятся на ишемические и геморрагические. Однако отличить их без специальной подготовки сложно. Даже опытный невролог, осмотрев пациента и проверив рефлексы, не всегда сможет точно определить, к какому типу относится острое нарушение мозгового кровообращения (ОНМК) – инфаркту или кровоизлиянию. Для точной диагностики требуются дополнительные инструментальные и лабораторные исследования, такие как КТ, осмотр глазного дна, коагулограмма, спинномозговая пункция и другие. Ниже представлены критерии, на которые опирается врач.
| Диагностический критерий | Геморрагический инсульт (кровоизлияние в мозг) | Ишемический инсульт (инфаркт мозга) |
|---|---|---|
| Возраст | Молодые люди 20–40 лет для субарахноидального кровоизлияния, старше 45–50 для кровоизлияния в ГМ | Обычно после 50 лет (эмболия возможна в любом возрасте) |
| Возможные предвестники | Чаще всего без предвестников или сильная головная боль | Преходящие очаговые неврологические симптомы |
| Внешние признаки, реакция кожных покровов | Покраснение лица, инъекции склер, блефароспазм (в зависимости от типа ОНМК) | Кожные покровы бледные или нормальные |
| Дебют заболевания | Внезапный приступ, обычно в дневное время (после стрессов или физических нагрузок) | Инфаркт мозга чаще происходит ночью или рано утром |
| Сознание | Быстрое развитие нарушений, иногда до комы | Постепенное нарастание симптомов |
| Головная боль | Часто выраженная | Иногда слабо выраженная |
| Двигательное возбуждение | Часто наблюдается | Редко |
| Наличие рвоты | До 80% случаев | До 5% (тромбоз), до 30% (эмболия) |
| Особенности дыхательной функции | Клокочущее дыхание, дыхательная аритмия, при субарахноидальном кровоизлиянии – дыхание Чейн-Стокса | Редкие нарушения |
| Характер пульса | Напряженный, редкий или учащенный | Слабый, учащенный |
| Парезы и параличи конечностей | Гемиплегия с гиперрефлексией или отсутствие рефлексов | Неравномерный гемипарез |
| Патологические рефлексы | С обеих сторон | С одной стороны |
| Скорость развития неврологической симптоматики | Быстрое развитие | Постепенное (тромбоз), быстрое – при эмболии |
| Развитие судорожного синдрома | Сравнительно редко, при субарахноидальном кровоизлиянии – до 30% | Редко (тромбоз), чаще – при эмболии |
| Менингеальные рефлексы | Часто наблюдаются | Иногда |
| Плавающий взор | Характерен | В редких случаях |
| Стволовые расстройства | Быстрое развитие | Медленное развитие |
| Спинномозговая жидкость | Повышенное давление, ликвор с примесью крови | Нормальное давление, ликвор прозрачный и бесцветный |
| Состояние артериальных сосудов глазного дна | Изменения калибра артерий, кровоизлияние | Преимущественно склеротические изменения |
В следующих разделах мы сравним этиологию, патогенез и симптомы ишемического и геморрагического инсульта.
Ишемический инсульт – острая форма церебральной ишемии
Ишемический инсульт — острая форма церебральной ишемии, чаще всего возникает на фоне атеросклероза, поражающего сосуды головного мозга, и сопутствующей артериальной гипертензии. Это заболевание в основном затрагивает пожилых людей, часто имеющих множество проблем со здоровьем, но не всегда осознающих серьезность своего состояния. У многих из них ишемия головного мозга протекает в хронической форме, проявляясь периодическими головными болями, головокружением, а также нарушениями памяти и внимания. У некоторых пациентов прогрессирующий процесс может привести к интеллектуально-мнестическим расстройствам и инвалидности.
К другим факторам, способствующим развитию острого нарушения мозгового кровообращения, относятся васкулиты, врожденные аномалии сосудов головного мозга, сахарный диабет, ревматизм, вредные привычки и нарушения системной гемодинамики (например, ишемическая болезнь сердца, аритмии с риском тромбоэмболий, проблемы с гемостазом). Важно выделить факторы, которые могут привести к острой церебральной ишемии:
- Возраст старше 50 лет (для мужчин этот порог может быть ниже) — в этом возрасте редко встречаются пациенты с абсолютно здоровыми сосудами, нормальным уровнем липидов и стабильным артериальным давлением.
- Повышенная вязкость крови и замедленное движение по сосудам.
- Нарушения обмена жиров — это актуальная проблема современности, особенно у женщин в климактерический период: уровень эстрогенов снижается, вес увеличивается, атеросклероз прогрессирует, артериальное давление поднимается, что увеличивает риск ишемического инсульта.
- Гематологические заболевания, приводящие к повышению свертываемости крови и избыточному образованию тромбов.
- Шейный остеохондроз и его последствия (например, вертебро-базилярная недостаточность).
- Нежелание отказаться от вредных привычек, приобретенных в молодости, среди которых курение занимает ведущее место.
Также стоит отметить, что ишемические инсульты у людей с вышеупомянутыми патологиями чаще возникают на фоне стресса, волнения или испуга, что подчеркивает важность эмоционального состояния в развитии этого заболевания.
Ишемический инсульт = инфаркт мозга
Врачи называют ишемический инсульт инфарктом головного мозга, так как его основная причина — тромбоз сосудов мозга, возникающий в области поврежденной бляшки. Когда целостность эндотелиального слоя бляшки нарушается, образуется тромб, который закупоривает артерию. В результате прекращается кровоснабжение тканей, что вызывает глубокую гипоксию и, как следствие, некроз. Так развивается инфаркт мозга или ишемический инсульт.
Ишемический инсульт, в отличие от геморрагического, часто имеет предвестники. К числу симптомов, которые могут служить первыми признаками приближающегося инсульта, относятся:
- Головокружение и общая слабость;
- Головная боль, которая может присутствовать, но обычно не выражена сильно, поэтому пациент может не обращать на нее внимания;
- Слабый пульс;
- Пониженное артериальное давление;
- Нормальная или субфебрильная температура тела;
- Кратковременные расстройства сознания (при настоящем остром нарушении мозгового кровообращения сознание, как правило, сохраняется);
- Потемнение в глазах;
- Временные парезы и парестезии.
Отсутствие кровоснабжения в определенной области головного мозга (наступление настоящего инфаркта мозга) проявляется быстро, приводя к острым состояниям.
Первые признаки инсульта практически идентичны симптомам транзиторной ишемической атаки (ТИА):
- Человек испытывает сильное головокружение;
- Наблюдается тошнота, часто с рвотой;
- Речь становится нечеткой (язык «заплетается»);
- В большинстве случаев нарушается зрение;
- Участки лица и тела, иннервируемые пораженной зоной, теряют чувствительность;
- Обращает на себя внимание нарушение ориентации во времени и пространстве, пациент не может вспомнить свой возраст, адрес проживания и т. д.;
- Быстро проявляются неврологические симптомы, такие как исчезновение чувствительности, появление патологических рефлексов и двигательные расстройства.
Неврологическая симптоматика не входит в круг обязательных знаний людей, чья работа не связана с медициной. Однако она может быть заметна внешне, особенно если слегка покалывать конечности пациента булавкой или иголкой — при нарушении чувствительности на уколы он не отреагирует.
Геморрагический инсульт – всегда тяжелое состояние
Геморрагический инсульт проявляется теми же симптомами, что и инфаркт мозга. Однако он:
чаще сопровождается потерей сознания, более стремительным развитием симптомов и всегда значительными неврологическими нарушениями.
Это связано с нарушением церебрального кровообращения из-за разрыва стенки сосуда, что приводит к излиянию крови и образованию гематомы, или к пропитыванию нервной ткани кровью.
Если поврежден крупный сосуд и затронут значительный участок мозга, вскоре наблюдается резкое увеличение внутричерепного давления и быстрое развитие неврологических симптомов. Клинические проявления острого нарушения мозгового кровообращения геморрагического типа зависят от локализации и размеров очага поражения, а также от того, какие мозговые структуры подверглись патологическому воздействию. Это означает, что первые признаки инсульта указывают на нарушения определенных функций мозга. В большинстве случаев на первый план выходят двигательные и чувствительные расстройства.
Инсульт и кровоизлияние в чем разница?
Некоторые люди ошибочно считают, что между кровоизлиянием и инсультом можно поставить знак «равно». На самом деле, эти термины не идентичны. Геморрагический инсульт всегда является кровоизлиянием, но кровоизлияние не всегда является инсультом.
Геморрагическим инсультом, или острым нарушением мозгового кровообращения геморрагического типа, называют образование гематомы, возникающее из-за разрыва сосуда или пропитывания нервной ткани кровью через стенки сосудов. Это чаще всего происходит на фоне высокого артериального давления у людей с артериальной гипертензией, которые пережили множество гипертонических кризов. Гипертонический криз может стать причиной кровоизлияния в головной мозг. Стенки сосудов могут долго выдерживать давление, но при новом кризе, подвергаясь патологическим изменениям, они могут не справиться с нагрузкой и разорваться.
Что касается вторичных кровоизлияний, возникающих под воздействием других факторов (различные патологические состояния, не связанные с постоянным повышением артериального давления или изменениями в сосудах), то в таких случаях, несмотря на проявление симптомов инсульта, термин «инсульт» обычно не используется.
Почти всегда внезапный и неожиданный
Вряд ли пациенты с артериальной гипертензией, частыми гипертоническими кризами или аневризмами и сосудистыми мальформациями, о которых они могут не подозревать, осознают риск инсульта. Обычно люди надеются, что неприятности их обойдут, и поэтому часто легкомысленно относятся к своей гипертензии и кризам. Однако, когда пациент, доставленный в больницу, слышит пугающее слово «инсульт», он удивляется, почему именно ему выпала такая участь. К сожалению, не всем удается избежать подобных размышлений при остром нарушении мозгового кровообращения. Геморрагический инсульт зачастую не оставляет шансов на выживание.
Геморрагический инсульт «моложе» ишемического, и его внезапное проявление у молодых людей не удивляет специалистов. В отличие от инфаркта мозга, кровоизлияние обычно происходит в дневное время на фоне повышенного артериального давления, и человек, как правило, не предчувствует надвигающейся катастрофы. Для геморрагического инсульта не характерны предвестники, как это бывает при ишемии головного мозга.
Таким образом, первые признаки инсульта (геморрагический тип):
- Потеря сознания во время скачка артериального давления (в условиях кризиса, эмоциональной или физической нагрузки);
- Вегетативные симптомы (потливость, повышение температуры тела, покраснение лица, реже – бледность кожи);
- Нарушение дыхания и сердечного ритма;
- Возможное развитие коматозного состояния.
Основной причиной кровоизлияния является артериальная гипертензия. Значительную роль в формировании предпосылок для инсульта играют аневризмы и мальформации. Кроме того, к развитию этого типа острого нарушения мозгового кровообращения могут привести заболевания, такие как сахарный диабет, нарушения липидного обмена, гематологические болезни, сопровождающиеся снижением свертываемости крови, наследственность и атеросклероз, который негативно влияет на состояние сосудистой стенки (изъязвление, истончение). Использование антикоагулянтов, антиагрегантов и фибринолитиков, а также нежелание расстаться с вредными привычками также могут способствовать развитию этой серьезной патологии.
Диагноз и лечение
Несмотря на частое использование термина «инсульт» в разговорах врачей, пациентов и их близких, в медицинских документах его редко указывают как диагноз. Врач скорой помощи обычно записывает: ОНМК, а невролог может поставить один из следующих диагнозов:
- Гематома;
- Геморрагическое пропитывание;
- Инфаркт мозга.
К каждому из этих терминов добавляются данные о локализации поражения, что имеет ключевое значение для прогноза.
Важно отметить, что лечение инфаркта мозга и геморрагического инсульта в некоторых аспектах противоположно.
Например, антикоагулянты, назначаемые при ишемии, могут быть опасны при кровоизлиянии, так как они увеличивают размеры очага поражения (гематомы или пропитывания).
Попытка справиться с острым нарушением мозгового кровообращения, полагаясь на советы знакомых и соседей, не приведет к положительному результату. Даже если первые симптомы инсульта не вызывают сильного беспокойства из-за их незначительности, только срочная медицинская помощь в острый период и строгое соблюдение рекомендаций лечащего врача в процессе восстановления помогут минимизировать остаточные эффекты, которые могут сохраняться на протяжении всей жизни пациента.
Видео: как распознать инсульт – мнение специалиста
Вопрос-ответ
В чем отличия ишемического и геморрагического инсульта?
Отличие от ишемического инсульта. Основным различием является то, что при геморрагической форме к нарушению работы мозга приводит кровоизлияние, а при ишемической — нарушение кровообращения, вызванное закупоркой сосудов, что приводит к кислородному голоданию и отмиранию части мозга.
Какие первые признаки инсульта?
Первые признаки инсульта могут включать внезапную слабость или онемение лица, руки или ноги, особенно с одной стороны тела; затруднения в речи или понимании речи; внезапное ухудшение зрения на один или оба глаза; а также внезапную головную боль без известной причины. Если вы заметили эти симптомы, необходимо немедленно обратиться за медицинской помощью.
Каковы первые признаки ишемического инсульта?
Первые признаки ишемического инсульта могут включать внезапную слабость или онемение лица, руки или ноги, особенно с одной стороны тела; затруднения в речи или понимании речи; проблемы с координацией и равновесием; а также внезапное ухудшение зрения на одном или обоих глазах. Если вы заметили эти симптомы, необходимо немедленно обратиться за медицинской помощью.
Каковы 4 главных признака инсульта?
Четыре главных признака инсульта включают: внезапную слабость или онемение лица, руки или ноги, особенно с одной стороны тела; затруднения в речи или понимании; внезапное ухудшение зрения на один или оба глаза; а также внезапную головную боль без известной причины. Если вы заметили эти симптомы, необходимо немедленно обратиться за медицинской помощью.
Советы
СОВЕТ №1
Обратите внимание на внезапные изменения в состоянии здоровья. Если вы или кто-то из ваших близких испытывает резкое онемение или слабость в одной стороне тела, затруднения в речи или проблемы с координацией, немедленно обратитесь за медицинской помощью. Эти симптомы могут быть предвестниками инсульта.
СОВЕТ №2
Запомните акроним FAST для быстрого распознавания инсульта: F (Face – лицо) – проверьте, не опустилось ли одно из углов рта; A (Arms – руки) – попросите человека поднять обе руки; S (Speech – речь) – проверьте, не нарушена ли речь; T (Time – время) – если вы заметили хоть один из этих признаков, немедленно вызывайте скорую помощь.
СОВЕТ №3
Регулярно проходите медицинские обследования и следите за факторами риска инсульта, такими как высокое кровяное давление, диабет и высокий уровень холестерина. Поддержание здорового образа жизни, включая правильное питание и физическую активность, может значительно снизить вероятность инсульта.
СОВЕТ №4
Обучите своих близких признакам инсульта и важности быстрого реагирования. Чем больше людей будет осведомлено о симптомах инсульта, тем быстрее можно будет оказать необходимую помощь и минимизировать последствия.